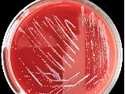

-
강지은기자2018.05.16 23:53:40
-
피부과 '집단패혈증' 프로포폴 오염 확인…1명 중환자실 입원
임재희기자2018.05.16 23:53:40
-
김지은기자2018.05.16 23:53:40
-
국토부 "반포 재건축 부담금 산정 문제 없어…조합원 2억 이득"
최희정기자2018.05.16 23:53:40
-
'원희룡 41.0% vs 문대림 36.8%'…제주지사 후보 여론조사
강정만기자2018.05.16 23:53:40
-
김지현기자2018.05.16 23:53:40
-
금융위 "바이오로직스, 삼성 경영권승계 관련여부 논의될 것"
이승주기자2018.05.16 23:53:40
-
우장호기자2018.05.16 23:53:40
-
세계 10억 무슬림, 17일부터 '라마단'...한달간 금식 수행
김재영기자2018.05.16 23:53:40
-
대입개편 시나리오 이틀간 뚝딱?…의견수렴 졸속 추진 우려
백영미기자2018.05.16 23:53:40
-
조인우기자2018.05.16 23:53:40
-
김환기, '붉은 점화' 시작가 80억 경매…한국 기록 갈아치울까
박현주기자2018.05.16 23:53:40
-
"宋, 맥스선더에 B-52 전개 안되게 했다" 발언 논란
김성진기자2018.05.16 23:53:39
-
문예성기자2018.05.16 23:53:39
-
변해정기자2018.05.16 23:53:39
-
강원랜드 수사 관련 "문무일 실질적 압력" vs "정당"
나운채기자2018.05.16 23:53:39
-
김양수기자2018.05.16 23:53:39
-
김경원기자2018.05.16 23:53:39
-
여야, 추경 심사 개시…상임위서 '속도전' 반발 잇따라
이재우기자2018.05.16 23:53:39
-
이혜원2기자2018.05.16 23:53:39
-
기재부, KT&G 사장 인사 개입 의혹…"동향 파악" 해명
변해정기자2018.05.16 23:53:39
-
검사장 '관용차 제공' 차관급 예우·평검사 귀족근무 폐지
나운채기자2018.05.16 23:53:39
-
현대모비스 대표 "지주사 전환 법령상 안돼…분할·합병 찬성 부탁"
박주연기자2018.05.16 23:53:39
-
홍찬선기자2018.05.16 23:53:39
- [속보]美, 이란의 호르무즈 통행료 징수 인정…파르스 통신
- '비상계엄 가담' 경찰 고위급 22명 징계…2명 해임·4명 강등
- "인천 훼손 시신, 키 161~165㎝ 성인 추정"
- [속보]국힘, 긴급 최고위 "서울 등 5곳 전면 재선거 소청"
- [속보]수도권 레미콘 파업 종료 수순…2차 잠정합의안 가결
- 이화영 진술 신빙성 공방…"주장 번복" vs "거짓말탐지기 진실"
- 레바논 언론 "이스라엘, 美·이란 합의에도 공격 계속"
- [속보]최태원-노소영 '재산 분할' 파기환송심 조정 불성립
- [속보]코스피, 미·이란 종전 합의에 5% 급등한 8545.98 마감
- [속보]종전 합의에 삼성전자 4%·SK하이닉스 6% 상승 마감
- [속보]원·달러 환율, 8.7원 내린 1511.1원 마감
- 트럼프, 다음은 러-우 전쟁?…중간선거 앞두고 '종식' 노림수
- [속보] 홍정도 중앙그룹 부회장 "일부 계열사 회생 절차 신청…진심으로 죄송"
- 경찰, '300억대 사기 의혹' 차가원 구속영장 신청
- 김종철 위원장 "불법촬영물 유통 수익 용인 안돼…플랫폼 책임져야"
- [속보] 김종철 방미통위원장 "조만간 쿠팡 납치광고건 제재 절차 개시"
- 휴전도 무색했던 美·이란 보복전…종전 뒤 '60일 핵협상' 남았다
- [속보]日닛케이지수 장중 사상 최고치…6만9000선 돌파
- 이란 최고지도자, 美 휴전 합의 전격 승인…"모든 군사작전 즉시 종료"
- 이란 매체, 합의문 초안 공개…"3000억 달러 재건 계획 포함" 주장